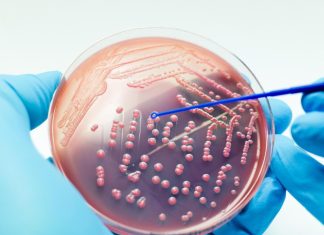
علماء روس يبتكرون مادة تصدر أشعة قاتلة للبكتيريا علماء روس يبتكرون مادة تصدر أشعة قاتلة للبكتيريا

كلمات البحث السودان
بطاقة: السودان
تشكيل لجنة وطنية للتحقيق في مزاعم الأسلحة الكيميائية
أفريقيا برس - السودان. اصدر رئيس مجلس السيادة الانتقالي قرارا بتشكيل لجنة وطنية للتحقيق في المزاعم الأمريكية حول استخدام الجيش السوداني لأسلحة كيميائية خلال...
تقييد حركة السائقين المصريين داخل الأراضي السودانية
أفريقيا برس - السودان. وجه جهاز تنظيم النقل البري الداخلي والدولي التابع لوزارة النقل المصرية، تقييد حركة السائقين المصريين داخل الأراضي السودانية على الولاية...
البرهان يرد على اتهامات أمريكية باستخدام أسلحة كيميائية
أفريقيا برس - السودان. أصدر رئيس مجلس السيادة الانتقالي قائد الجيش السوداني الفريق اول ركن عبد الفتاح البرهان، قراراً قضى بتشكيل لجنة وطنية تضم...
رئيس الوزراء كامل إدريس يصل السودان لتولي مهامه رسميًا ويسجد شكرًا
أفريقيا برس - السودان. وصل رئيس الوزراء د. كامل إدريس مساء اليوم الخميس الى العاصمة المؤقتة بورتسودان، استعدادًا لأداء القسم وتولي مهامه بشكل رسمي...
حكم بالإعدام مسؤول توزيع الأسلحة على إرتكازات الدعم السريع
أفريقيا برس - السودان. اصدرت محكمة جنايات أم درمان العامة برئاسة الهادي محمد الامين حكما بالإعدام شنقا حتى الموت تعزيرا في مواجهة المتهم (ص...
علماء روس يبتكرون مادة تصدر أشعة قاتلة للبكتيريا
أفريقيا برس - السودان. ابتكر علماء روس مادة جديدة قادرة على إصدار ضوء فوق بنفسجي لمدة قياسية تصل إلى 40 دقيقة، مما يؤدي إلى...
الإيقاع بشبكة قراصنة روسية بعد جهود عالمية مشتركة
أفريقيا برس - السودان. تضافرت جهود قوات الأمن في أوروبا وأميركا الشمالية معا من أجل الإيقاع بمجموعة من القراصنة الروس الذين عاثوا فسادا في...
المشتري كان ضعف حجمه الحالي في الماضي البعيد
أفريقيا برس - السودان. فَجَّر مجموعة من باحثي جامعة كالتيك الأميركية مفاجأة جديدة تخص مجموعتنا الشمسية، فكوكب المشتري، أكبر كواكبها في الحجم والذي يمكنه...
انتكاسة جديدة لبرنامج صواريخ “ستارشيب” الخاص بإيلون ماسك
أفريقيا برس - السودان. في انتكاسة جديدة لبرنامج صواريخ "ستارشيب"، فشلت شركة "سبيس إكس" في إتمام أهداف رحلتها التجريبية التاسعة، رغم وصول المركبة إلى...
صيف معتدل للمنطقة العربية دون موجات حر كبرى
أفريقيا برس - السودان. مع اقتراب بداية فصل الصيف، تزداد الحاجة إلى فهم توقعات الطقس والاطلاع على تحليلات دقيقة مبنية على بيانات علمية حديثة...